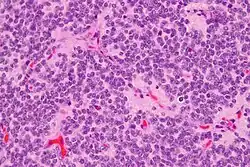

Центральная нейроцитома

Центральная нейроцитома — чрезвычайно редкая, обычно доброкачественная внутрижелудочковая опухоль головного мозга, которая обычно образуется из нейрональных клеток прозрачной перегородки.[1] Большинство центральных нейроцитом прорастают внутрь в желудочковую систему. Это приводит к двум основным неврологическим симптомам: нечеткости зрения и повышению внутричерепного давления. Лечение центральной нейроцитомы обычно включает хирургическое удаление с вероятностью рецидива примерно в 1 из 5 случаев.[2] Центральные нейроцитомы классифицируются как grade II опухоли в соответствии с классификацией опухолей нервной системы ВОЗ.[3][4]
Эпидемиология
Центральная нейроцитома составляют 0,1-0,5% первичных опухолей головного мозга.[5][6] В формировании этих опухолей есть генетический компонент, из-за которого у людей азиатского происхождения образуется эта опухоль развивается чаще, чем у представителей других этнических групп.[7] Центральные нейроцитомы преимущественно образуются у молодых людей, чаще всего в течение второго или третьего десятилетия жизни.[8] Нет никаких доказательств того, что пол человека каким-либо образом влияет на частоту центральных нейроцитом.[7]
Локализация
Центральные нейроцитомы обычно располагаются супратенториально в боковом желудочке(боковых желудочках) и/или третьем желудочке. Наиболее частым местом является передняя часть одного из боковых желудочков с последующим распространением в другой боковой и третий желудочки. Вовлечение прозрачной перегородки вероятно является особенностью опухоли.[9] Изолированное поражение третьего и четвертого желудочков встречается редко.[10]
Симптомы
Спектр жалоб пациентов с нейроцитомой обширен, большинство из них обусловлены обструктивной гидроцефалией, вследствие закупорки тока ликвора по желудочковой системе головного мозга. Наиболее частые симптомы:[11]
- Повышение внутричерепного давления
- Головная боль
- Отек диска зрительного нерва
- Рвота
- Головокружение
- Нарушение умственной деятельности
- Нестабильность походки
В редких и крайних случаях могут наблюдаться более серьезные симптомы:
- Нарушение памяти
- Слабоумие
- Гемипарез
- Судороги
- Кровоизлияние
- Психоз
Морфология
Макроскопически центральная нейроцитома имеет сероватый цвет, напоминающий серое вещество с участками кровоизлияния. Опухоль мягкой консистенции, овоидной формы, дольчатого или узловатых строения, которые обычно четко очерчены. На разрезе можно отметить некоторую шероховатость, которую связывают с кальцификацией.
Микроскопически опухоль представляет собой хорошо дифференцированное новообразование с доброкачественными гистологическими особенностями. Опухоль состоит из «одинаковых клеток малого и среднего размера с округлыми ядрами, мелко пунктирным хроматином и незаметными ядрышками, а также скудной цитоплазмой». Опухоль характеризуются периваскулярными и похожими на пинеоцитоматозные псевдорозетками, которые напоминают цветы расположением клеток, с небольшим кровеносным сосудом в центре. Опухолевые клетки расположены плотно в некоторых областях опухоли, но другие области являются безъядерными, менее плотными частями опухоли. Безъядерные области могут иметь тонкий фибриллярный матрикс , как и в областях нейропиля. Длинные тонкостенные сосуды размером с капилляр являются сосудистой системой нейроцитомы. Эти сосуды линейно разветвляются и имеют эндокринный вид. Тонкостенные расширенные сосудистые каналы, а также очаги кальцификации встречаются часто.[11]
Дифференциальный диагноз проводят с олигодендроглиомой.
Малое увеличение
Среднее увеличение
Среднее увеличение
Очень большое увеличение
Примечания
- ↑ A. Kerkeni, Z. Ben Lakhdher, M. Rkhami, R. Sebai, L. Belguith. [Central neurocytoma: Study of 32 cases and review of the literature] // Neuro-Chirurgie. — 2010-10. — Т. 56, вып. 5. — С. 408–414. — ISSN 1773-0619. — doi:10.1016/j.neuchi.2010.07.001.
- ↑ Jin Wook Kim, Dong Gyu Kim, Hyun-Tai Chung, Seung Hong Choi, Jung Ho Han. Radiosurgery for central neurocytoma: long-term outcome and failure pattern // Journal of Neuro-Oncology. — 2013-12. — Т. 115, вып. 3. — С. 505–511. — ISSN 1573-7373. — doi:10.1007/s11060-013-1253-9.
- ↑ David N. Louis, Hiroko Ohgaki, Otmar D. Wiestler, Webster K. Cavenee, Peter C. Burger. The 2007 WHO classification of tumours of the central nervous system // Acta Neuropathologica. — 2007-08. — Т. 114, вып. 2. — С. 97–109. — ISSN 0001-6322. — doi:10.1007/s00401-007-0243-4. Архивировано 16 ноября 2020 года.
- ↑ WHO classification of tumours of the central nervous system. — Revised 4th edition. — Lyon. — 408 pages с. — ISBN 978-92-832-4492-9, 92-832-4492-3. Архивировано 1 августа 2018 года.
- ↑ Ming-Tsung Chuang, Wei-Chen Lin, Huei-Yi Tsai, Gin-Chung Liu, Shih-Wen Hu. 3-T proton magnetic resonance spectroscopy of central neurocytoma: 3 case reports and review of the literature // Journal of Computer Assisted Tomography. — 2005-09. — Т. 29, вып. 5. — С. 683–688. — ISSN 0363-8715. — doi:10.1097/01.rct.0000171240.95430.29.
- ↑ Roxanna M. Garcia, Michael E. Ivan, Taemin Oh, Igor Barani, Andrew T. Parsa. Intraventricular neurocytomas: a systematic review of stereotactic radiosurgery and fractionated conventional radiotherapy for residual or recurrent tumors // Clinical Neurology and Neurosurgery. — 2014-02. — Т. 117. — С. 55–64. — ISSN 1872-6968. — doi:10.1016/j.clineuro.2013.11.028.
- 1 2 Mehar Chand Sharma, Prabal Deb, Suash Sharma, Chitra Sarkar. Neurocytoma: a comprehensive review // Neurosurgical Review. — 2006-10. — Т. 29, вып. 4. — С. 270–285; discussion 285. — ISSN 0344-5607. — doi:10.1007/s10143-006-0030-z. Архивировано 3 апреля 2022 года.
- ↑ J. Hassoun, F. Söylemezoglu, D. Gambarelli, D. Figarella-Branger, K. von Ammon. Central neurocytoma: a synopsis of clinical and histological features // Brain Pathology (Zurich, Switzerland). — 1993-07. — Т. 3, вып. 3. — С. 297–306. — ISSN 1015-6305. — doi:10.1111/j.1750-3639.1993.tb00756.x. Архивировано 3 апреля 2022 года.
- ↑ James L. Leenstra, Fausto J. Rodriguez, Christina M. Frechette, Caterina Giannini, Scott L. Stafford. Central neurocytoma: management recommendations based on a 35-year experience // International Journal of Radiation Oncology, Biology, Physics. — 2007-03-15. — Т. 67, вып. 4. — С. 1145–1154. — ISSN 0360-3016. — doi:10.1016/j.ijrobp.2006.10.018. Архивировано 3 апреля 2022 года.
- ↑ Alexandre Vasiljevic, Patrick François, Anderson Loundou, Michelle Fèvre-Montange, Anne Jouvet. Prognostic factors in central neurocytomas: a multicenter study of 71 cases // The American Journal of Surgical Pathology. — 2012-02. — Т. 36, вып. 2. — С. 220–227. — ISSN 1532-0979. — doi:10.1097/PAS.0b013e31823b8232. Архивировано 3 апреля 2022 года.
- 1 2 Yu Li, Xiu-Feng Ye, Guo Qian, Yu Yin, Qian-Guan Pan. Pathologic features and clinical outcome of central neurocytoma: analysis of 15 cases // Chinese Journal of Cancer Research = Chung-Kuo Yen Cheng Yen Chiu. — 2012-12. — Т. 24, вып. 4. — С. 284–290. — ISSN 1000-9604. — doi:10.3978/j.issn.1000-9604.2012.08.02.